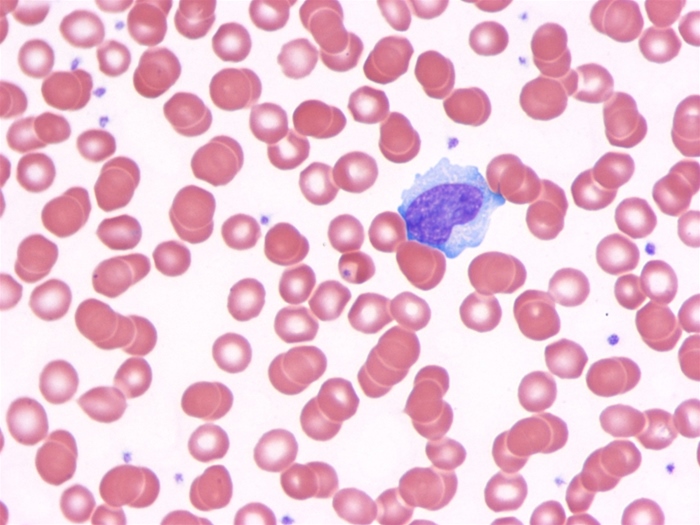
A 16-year-old previously healthy boy is brought to the office due to fever, malaise, and sore throat.  The patient says that he gets tired even by simply getting out of bed.  Physical examination shows palatal petechiae, cervical lymphadenopathy, and splenomegaly.  His peripheral blood smear is shown in the image below.   Horse erythrocytes agglutinate when exposed to the patient's serum.  The agent causing this patient's disease is most strongly associated with which of the following malignancies? A) Acute myeloid leukemia B) Cervical carcinoma C) Hepatocellular carcinoma D) Kaposi sarcoma E) Mucosa-associated lymphoid tissue tumor F) Multiple myeloma G) Nasopharyngeal carcinoma

A 16-year-old previously healthy boy is brought to the office due to fever, malaise, and sore throat. The patient says that he gets tired even by simply getting out of bed. Physical examination shows palatal petechiae, cervical lymphadenopathy, and splenomegaly. His peripheral blood smear is shown in the image below. Horse erythrocytes agglutinate when exposed to the patient's serum. The agent causing this patient's disease is most strongly associated with which of the following malignancies?
Horse erythrocytes agglutinate when exposed to the patient's serum. The agent causing this patient's disease is most strongly associated with which of the following malignancies?
A) Acute myeloid leukemia
B) Cervical carcinoma
C) Hepatocellular carcinoma
D) Kaposi sarcoma
E) Mucosa-associated lymphoid tissue tumor
F) Multiple myeloma
G) Nasopharyngeal carcinoma
Correct Answer:
Verified
Q389: A 28-year-old previously healthy man comes to
Q390: A 35-year-old woman comes to the office
Q391: A 26-year-old woman, gravida 2 para 1,
Q392: A 32-year-old Caucasian woman experiences three episodes
Q393: A 26-year-old Caucasian female is found to
Q395: A 16-year-old girl comes to the office
Q396: A 64-year-old man is brought to the
Q397: A 20-year-old man is evaluated for recurrent
Q398: A 15-year-old girl is evaluated due to
Q399: A 59-year-old woman comes to the office
Unlock this Answer For Free Now!
View this answer and more for free by performing one of the following actions

Scan the QR code to install the App and get 2 free unlocks

Unlock quizzes for free by uploading documents